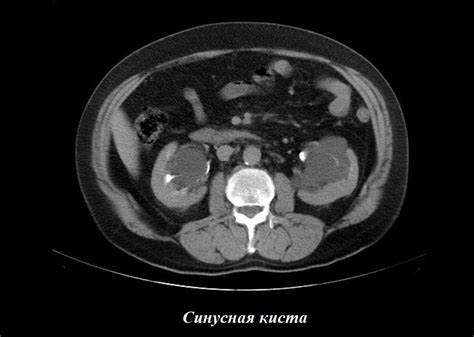
Синусные кисты почек: лечение, симптомы, причины возникновения, чем опасны Картинка - Синусные кисты почек: лечение, симптомы, причины возникновения, чем опасны

Кисты почек диета

 Картинка 2: Парапельвикальная киста почки: что это такое, причины возникновения
Картинка 2: Парапельвикальная киста почки: что это такое, причины возникновения
 Картинка 3: Ультразвуковая диагностика заболеваний почек. Анатомия почек и
Картинка 3: Ультразвуковая диагностика заболеваний почек. Анатомия почек и
 Картинка 4: Лечение кисты почек народными средствами в домашних условиях эффективно
Картинка 4: Лечение кисты почек народными средствами в домашних условиях эффективно
 Картинка 5: Лучевая диагностика заболеваний почек - презентация онлайн
Картинка 5: Лучевая диагностика заболеваний почек - презентация онлайн
 Картинка 6: Кисты почек босниак - Почки
Картинка 6: Кисты почек босниак - Почки
 Картинка 7: Лечение кисты почек медикаментозно: действенные препараты
Картинка 7: Лечение кисты почек медикаментозно: действенные препараты
 Картинка 8: МРТ почек. Перипельвикальные кисты. | Портал радиологов
Картинка 8: МРТ почек. Перипельвикальные кисты. | Портал радиологов
 Картинка 9: Киста почек на КТ - УЗИ или томография при кисте почек
Картинка 9: Киста почек на КТ - УЗИ или томография при кисте почек
 Картинка 10: Кисты почек. Классификация по Bosniak.
Картинка 10: Кисты почек. Классификация по Bosniak.
 Картинка 11: Здоровье почек: Диета для гриппа Henoch-Schonlein Purpura Nephritis
Картинка 11: Здоровье почек: Диета для гриппа Henoch-Schonlein Purpura Nephritis
 Картинка 12: Ультразвуковое исследование (УЗИ) почек
Картинка 12: Ультразвуковое исследование (УЗИ) почек
 Картинка 13: Синусная киста почки (парапельвикальная / перипельвикальная киста)
Картинка 13: Синусная киста почки (парапельвикальная / перипельвикальная киста)
 Картинка 14: Читайте о Парапельвикальные кисты почек что это такое исход заболевания
Картинка 14: Читайте о Парапельвикальные кисты почек что это такое исход заболевания
 Картинка 15: Классификация кист почек: по МКБ 10 и Босняку, парапельвикальные
Картинка 15: Классификация кист почек: по МКБ 10 и Босняку, парапельвикальные
 Картинка 16: Парапельвикальные кісти нирок та їх лікування
Картинка 16: Парапельвикальные кісти нирок та їх лікування
 Картинка 17: Классификация кист почек по Босниак: признаки
Картинка 17: Классификация кист почек по Босниак: признаки
 Картинка 18: Киста почки - Клиника 29
Картинка 18: Киста почки - Клиника 29
 Картинка 19: Синусные кисты почек: лечение, симптомы, причины возникновения, чем опасны
Картинка 19: Синусные кисты почек: лечение, симптомы, причины возникновения, чем опасны
 Картинка 20: Кисты почек. Классификация по Bosniak.
Картинка 20: Кисты почек. Классификация по Bosniak.
 Картинка 21: Причины поликистоза и кисты на почке: что делать, лечение народными
Картинка 21: Причины поликистоза и кисты на почке: что делать, лечение народными
 Картинка 22: Кисты почек - презентация онлайн
Картинка 22: Кисты почек - презентация онлайн
 Картинка 23: Причины поликистоза и кисты на почке: что делать, лечение народными
Картинка 23: Причины поликистоза и кисты на почке: что делать, лечение народными
 Картинка 24: Синусная киста почки: симптомы и признаки кисты синуса правой, левой и
Картинка 24: Синусная киста почки: симптомы и признаки кисты синуса правой, левой и
 Картинка 25: Как лечить кисту на почке без операции традиционными методами | spravki1.ru
Картинка 25: Как лечить кисту на почке без операции традиционными методами | spravki1.ru
 Картинка 26: Множественные кисты почек: причины возникновения, чем опасны, симптомы
Картинка 26: Множественные кисты почек: причины возникновения, чем опасны, симптомы
 Картинка 27: Лечение кисты почки у женщин и мужчин
Картинка 27: Лечение кисты почки у женщин и мужчин
 Картинка 28: Парацервикальные Кисты Почек Что Это Такое Исход Заболевания
Картинка 28: Парацервикальные Кисты Почек Что Это Такое Исход Заболевания
 Картинка 29: Читайте о Парапельвикальные кисты почек что это такое исход заболевания
Картинка 29: Читайте о Парапельвикальные кисты почек что это такое исход заболевания
 Картинка 30: Почки, КТ-диагностика
Картинка 30: Почки, КТ-диагностика
 Картинка 31: Киста почки. УЗИ характеристика простой и коплексной кисты
Картинка 31: Киста почки. УЗИ характеристика простой и коплексной кисты
 Картинка 32: Патология живота. Кисты почек (Хофер М. "Компьютерная томография
Картинка 32: Патология живота. Кисты почек (Хофер М. "Компьютерная томография
 Картинка 33: Кисты почек КАК избавиться без операции - YouTube
Картинка 33: Кисты почек КАК избавиться без операции - YouTube
 Картинка 34: Киста почки лечение
Картинка 34: Киста почки лечение
 Картинка 35: Парапельвикальные кисты почек
Картинка 35: Парапельвикальные кисты почек
 Картинка 36: Диета после голодания после приступа панкреатита - фото презентация
Картинка 36: Диета после голодания после приступа панкреатита - фото презентация
 Картинка 37: Терапия кисты почек народными средствами в домашних уловиях: способы
Картинка 37: Терапия кисты почек народными средствами в домашних уловиях: способы
 Картинка 38: Кисты почек - презентация онлайн
Картинка 38: Кисты почек - презентация онлайн
 Картинка 39: Кисты почек. Этиология. Классификация - презентация, доклад, проект
Картинка 39: Кисты почек. Этиология. Классификация - презентация, доклад, проект
 Картинка 40: Кисты на почках у женщин что такое
Картинка 40: Кисты на почках у женщин что такое
 Картинка 41: Множественные кисты почек: причины возникновения, чем опасны, симптомы
Картинка 41: Множественные кисты почек: причины возникновения, чем опасны, симптомы
 Картинка 42: От чего образуются кисты на почках: Киста почек: симптомы, диагностика
Картинка 42: От чего образуются кисты на почках: Киста почек: симптомы, диагностика
 Картинка 43: Диета при поликистозе почек: правила питания, меню на каждый день
Картинка 43: Диета при поликистозе почек: правила питания, меню на каждый день
 Картинка 44: Кисты почек - презентация онлайн
Картинка 44: Кисты почек - презентация онлайн
 Картинка 45: Киста почек на КТ - УЗИ или томография при кисте почек
Картинка 45: Киста почек на КТ - УЗИ или томография при кисте почек
 Картинка 46: Лечение кисты почек медикаментозно: действенные препараты
Картинка 46: Лечение кисты почек медикаментозно: действенные препараты
 Картинка 47: От чего образуются кисты на почках: Киста почек: симптомы, диагностика
Картинка 47: От чего образуются кисты на почках: Киста почек: симптомы, диагностика
 Картинка 48: Кисты и гемангиомы печени. Причины. Диагностика. Лечение. - YouTube
Картинка 48: Кисты и гемангиомы печени. Причины. Диагностика. Лечение. - YouTube
 Картинка 49: Кисты почек - презентация онлайн
Картинка 49: Кисты почек - презентация онлайн
 Картинка 50: Система диет по певзнеру таблица - Все о диетах
Картинка 50: Система диет по певзнеру таблица - Все о диетах
 Картинка 51: Что такое солитарная киста почки
Картинка 51: Что такое солитарная киста почки
 Картинка 52: Киста печени по классификации bosniak - фото презентация
Картинка 52: Киста печени по классификации bosniak - фото презентация
 Картинка 53: Лапароскопическая операция кисты почек | Клиника урологии Первого МГМУ
Картинка 53: Лапароскопическая операция кисты почек | Клиника урологии Первого МГМУ
 Картинка 54: Лечение кисты почки в Хабаровске - Медикъ
Картинка 54: Лечение кисты почки в Хабаровске - Медикъ
 Картинка 55: Киста почки - симптомы и лечение - блог Медюнион
Картинка 55: Киста почки - симптомы и лечение - блог Медюнион
 Картинка 56: Питание при панкреатите: заболевании поджелудочной железы
Картинка 56: Питание при панкреатите: заболевании поджелудочной железы
Картинка 57: Пункция кисты почек - YouTube
Картинка 57: Пункция кисты почек - YouTube
 Картинка 58: Кисты почек. Что это, какие бывают, что делать? - YouTube
Картинка 58: Кисты почек. Что это, какие бывают, что делать? - YouTube
 Картинка 59: КІСТА НИРКИ Лікування у Дніпрі ⋮ MEDICAL PLAZA
Картинка 59: КІСТА НИРКИ Лікування у Дніпрі ⋮ MEDICAL PLAZA
 Картинка 60: Киста почки: симптомы, причины и лечение
Картинка 60: Киста почки: симптомы, причины и лечение